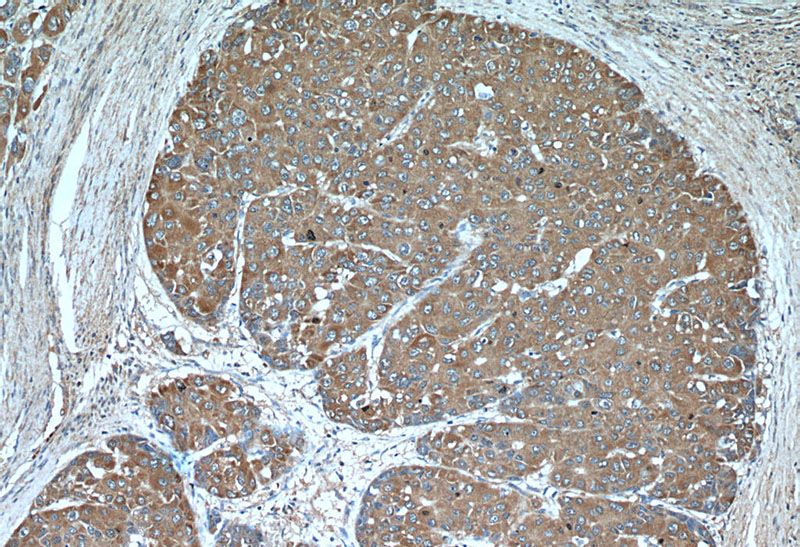
Immunohistochemical of paraffin-embedded human liver cancer using Catalog No:110907(GCLM antibody) at dilution of 1:50 (under 10x lens)

-
Product Name
GCLM antibody
- Documents
-
Description
GCLM Rabbit Polyclonal antibody. Positive IF detected in HepG2 cells. Positive IHC detected in human liver cancer tissue, human skeletal muscle tissue. Positive FC detected in HepG2 cells. Positive WB detected in A431 cells, K-562 cells, L02 cells, MCF7 cells. Positive IP detected in A431 cells. Observed molecular weight by Western-blot: 31 kDa
-
Tested applications
ELISA, WB, IHC, IF, FC, IP
-
Species reactivity
Human,Mouse,Rat; other species not tested.
-
Alternative names
Gamma ECS regulatory subunit antibody; GCLM antibody; GCS light chain antibody; GLCLR antibody
- Immunogen
-
Isotype
Rabbit IgG
-
Preparation
This antibody was obtained by immunization of GCLM recombinant protein (Accession Number: NM_002061). Purification method: Antigen affinity purified.
-
Clonality
Polyclonal
-
Formulation
PBS with 0.02% sodium azide and 50% glycerol pH 7.3.
-
Storage instructions
Store at -20℃. DO NOT ALIQUOT
-
Applications
Recommended Dilution:
WB: 1:200-1:2000
IP: 1:500-1:5000
IHC: 1:20-1:200
IF: 1:20-1:200
-
Validations

A431 cells were subjected to SDS PAGE followed by western blot with Catalog No:110907(GCLM antibody) at dilution of 1:500
Immunohistochemical of paraffin-embedded human liver cancer using Catalog No:110907(GCLM antibody) at dilution of 1:50 (under 10x lens)

Immunohistochemical of paraffin-embedded human liver cancer using Catalog No:110907(GCLM antibody) at dilution of 1:50 (under 40x lens)

Immunofluorescent analysis of HepG2 cells, using GCLM antibody Catalog No:110907 at 1:50 dilution and Rhodamine-labeled goat anti-rabbit IgG (red). Blue pseudocolor = DAPI (fluorescent DNA dye).

IP Result of anti-GCLM (IP:Catalog No:110907, 3ug; Detection:Catalog No:110907 1:1000) with A431 cells lysate 3040ug.

1X10^6 HepG2 cells were stained with 0.2ug GCLM antibody (Catalog No:110907, red) and control antibody (blue). Fixed with 90% MeOH blocked with 3% BSA (30 min). Alexa Fluor 488-congugated AffiniPure Goat Anti-Rabbit IgG(H+L) with dilution 1:1500.
-
Background
GCLM(Glutamate--cysteine ligase regulatory subunit) is also named as GLCLR and belongs to the aldo/keto reductase family. It catalyzes the first step of GSH synthesisand is involved in gamma-glutamyl cycle. GCLM is implicated in some forms of hemolytic anemia.
-
References
- Wu H, Xiao Y, Zhang S. The Ets transcription factor GABP is a component of the hippo pathway essential for growth and antioxidant defense. Cell reports. 3(5):1663-77. 2013.
- Gunjima K, Tomiyama R, Takakura K. 3,4-dihydroxybenzalacetone protects against Parkinson's disease-related neurotoxin 6-OHDA through Akt/Nrf2/glutathione pathway. Journal of cellular biochemistry. 115(1):151-60. 2014.
- Ma Q, Zhao J, Cao W, Liu J, Cui S. Estradiol decreases taurine level by reducing cysteine sulfinic acid decarboxylase via the estrogen receptor-α in female mice liver. American journal of physiology. Gastrointestinal and liver physiology. 308(4):G277-86. 2015.
- Snyder NW, Golin-Bisello F, Gao Y, Blair IA, Freeman BA, Wendell SG. 15-Oxoeicosatetraenoic acid is a 15-hydroxyprostaglandin dehydrogenase-derived electrophilic mediator of inflammatory signaling pathways. Chemico-biological interactions. 234:144-53. 2015.
- Brown-Borg HM, Rakoczy S, Wonderlich JA, Armstrong V, Rojanathammanee L. Altered dietary methionine differentially impacts glutathione and methionine metabolism in long-living growth hormone-deficient Ames dwarf and wild-type mice. Longevity & healthspan. 3(1):10. 2014.
- Ravuri C, Svineng G, Huseby NE. Differential regulation of γ-glutamyltransferase and glutamate cysteine ligase expression after mitochondrial uncoupling: γ-glutamyltransferase is regulated in an Nrf2- and NFκB-independent manner. Free radical research. 47(5):394-403. 2013.
- Yuan XH, Fan YY, Yang CR. Progesterone amplifies oxidative stress signal and promotes NO production via H2O2 in mouse kidney arterial endothelial cells. The Journal of steroid biochemistry and molecular biology. 155(Pt A):104-11. 2016.
Related Products / Services
Please note: All products are "FOR RESEARCH USE ONLY AND ARE NOT INTENDED FOR DIAGNOSTIC OR THERAPEUTIC USE"
